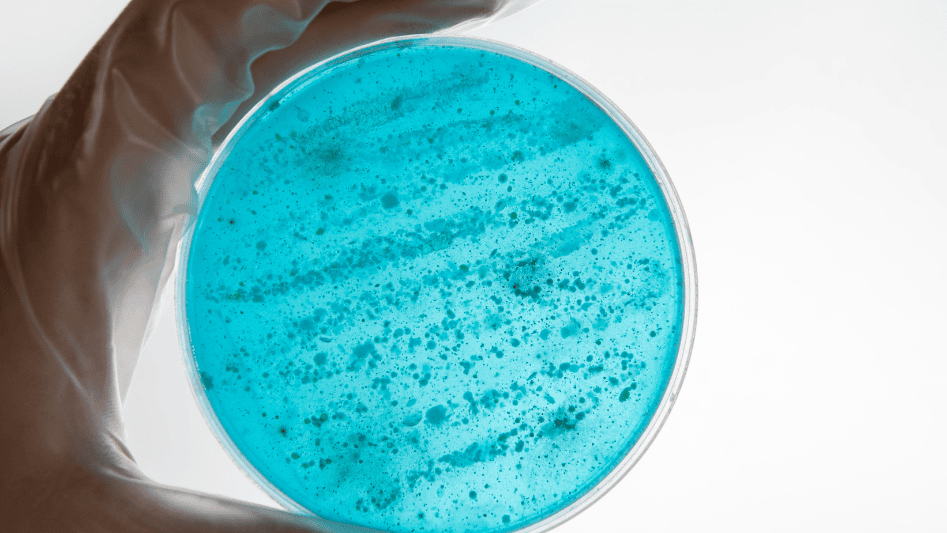
Gloved hand displaying a bacteria filter in a petri dish.

Advanced bacterial filter technology is extremely important in an era where sanitation and hygiene are more important than ever. GVS Malaysia has been in the forefront of creating cutting-edge bacterial filter solutions to satisfy the expanding needs of a range of sectors, such as laboratory settings, HVAC systems, and healthcare. This article examines GVS Malaysia’s most recent innovations in bacterial filter technology and emphasizes how they lead to surroundings that are safer and more effective.
What is a Bacterial Filter?
A bacterial filter is a device designed to remove bacteria and other microbial contaminants from air or fluids, typically using physical barriers or other filtration media. These filters are essential components in systems where sterility and air quality are critical, such as in operating rooms, sterile manufacturing facilities, and HVAC systems.
Recent Advancements in Bacterial Filter Technology by GVS Malaysia
1. Enhanced Filtration Efficiency:
- Description: GVS Malaysia has introduced bacterial filters with higher filtration efficiency, capable of trapping even smaller microparticles and bacteria than ever before. Utilizing advanced materials and manufacturing techniques, these filters achieve up to 99.999% efficiency in removing bacterial contaminants.
- Impact: This high level of efficiency ensures that air and fluids in medical settings, laboratories, and public spaces are free from harmful bacteria, thereby reducing the risk of infection and contamination.
2. Improved Air Flow Management:
- Description: Alongside enhanced filtration capabilities, GVS Malaysia’s latest bacterial filters are designed to optimize air flow. This is achieved through innovative filter designs that minimize air flow resistance, thereby enhancing the overall efficiency of ventilation systems.
- Impact: Improved air flow management not only aids in maintaining optimal indoor air quality but also reduces energy consumption by allowing HVAC systems to operate more efficiently.
3. Antimicrobial Coatings:
- Description: GVS Malaysia has also incorporated antimicrobial coatings into their bacterial filters. These coatings are specially formulated to kill bacteria upon contact, adding an additional layer of protection against microbial growth on the filter surface.
- Impact: The antimicrobial coatings help prolong the lifespan of the filters, reduce maintenance frequency, and provide ongoing protection against bacteria between filter changes.
4. Eco-Friendly Materials:
- Description: Recognizing the environmental impact of filter disposal, GVS Malaysia has committed to using eco-friendly materials in their bacterial filters. These materials are designed to be recyclable or biodegradable, reducing the environmental footprint of their products.
- Impact: The use of sustainable materials not only addresses environmental concerns but also meets the sustainability policies of many organizations looking to reduce their ecological impact.
Conclusion
GVS Malaysia’s advances in bacterial filter technology are a major step in improving air quality and safeguarding public health in a variety of contexts. GVS Malaysia guarantees that its bacterial filters satisfy the highest requirements of sustainability and efficiency by consistently developing and enhancing their goods, offering clients dependable, superior solutions.